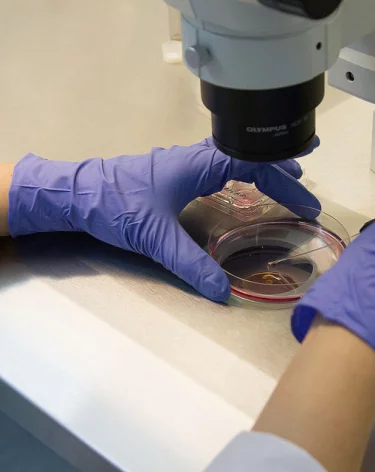
Выше температура и больше осложнений на сердце: чем опасен гонконгский грипп

Выше температура и больше осложнений на сердце: чем опасен гонконгский грипп
Выше температура и больше осложнений на сердце: чем опасен гонконгский грипп
Заболеваемость ОРВИ и гриппом в России растёт пятую неделю. В этом году по Европе и России гонконгский грипп A/H3N2 разгулялся особенно активно: мутировавший штамм выявляют более чем у 80% заболевших гриппом. Штамм не новый, а очень старый, но свежие мутации добавили врачам головной боли: теперь гонконгский грипп даёт больше осложнений — пневмонии, отитов и осложнений на сердце (миокардит при гриппе). Но это верно лишь для группы риска, а у большинства заражённых болезнь протекает легко.
Рассказываем, каковы симптомы гонконгского гриппа, как работает прививка и как проводится лечение гонконгского гриппа в России по рекомендациям врачей.
Потомок птичьего: что такое гонконгский грипп A/H3N2
Экзотическое имя носит потомок штамма гриппа A/H3N2 (гонконгский грипп), который впервые выделили в 1968–1969 годах в Гонконге. Он, в свою очередь, был потомком «азиатского» гриппа H2N2, который стал причиной пандемии 1957 года.
Штамм H3N2 тоже вызвал пандемию: распространился во Вьетнаме, Австралии, Африке и США и унёс, по разным подсчётам, от 0,5 до 4 миллионов жизней.
Штамм относится к серотипу А, семейству ортомиксовирусов. В отличие от серотипа В, вирус гриппа типа А (H3N2) заражает не только людей, но и животных — свиней, птиц и даже китов. Медики предполагают, что гонконгский грипп A/H3N2 — это мутировавший вирус гриппа птиц.
«Антигенный дрифт характерен для возбудителей гриппа, и в 2025 году штамм немного отличается от предыдущего. Но это абсолютно нормальное явление, это периодически происходит с вирусом гриппа», – подчёркивает Татьяна Бондаренко, главный областной специалист Кузбасса по инфекционным болезням у детей.

С тех пор штамм так или иначе выявляли каждый год. Наиболее массово гонконгский грипп распространился в 2016-2017 годах, когда приобрёл новый букет мутаций. В этом году от трети до половины заражений в Европе выделяют в отдельный подтип штамма — субкладу K.
Вирусы серотипа А вообще мутируют быстрее привычных нам штаммов типа В. Поэтому гонконгский грипп в России в 2025 году имеет к своему предку крайне отдалённое отношение. Как минимум он гораздо менее смертоносен, чем «прапрадедушка»: большинство заражённых болеют в лёгкой форме. А в Москве, по данным Роспотребнадзора, количество госпитализаций при гонконгском гриппе A/H3N2 в 2,5 раза меньше, чем в прошлом году.
Скорость и температура: симптомы гонконгского гриппа A/H3N2
Характерных особенностей у гонконгского гриппа A/H3N2 две. Во-первых — очень короткий инкубационный период, всего 1-2 дня от заражения до появления симптомов. Во-вторых, симптомы гриппа A/H3N2 чаще обычного манифестируют с высокой и очень высокой температурой тела — до 39,5 градуса.
В остальном симптомы гонконгского гриппа принципиально не отличаются от других вариантов гриппа и ОРВИ: головная боль, ломота в мышцах, покраснение глаз и светобоязнь, першение в горле, сухой кашель. Иногда присоединяются расстройства пищеварения, диарея. При тяжёлой форме заболевания возможны сыпь, рвота, обезвоживание.
Вирус гриппа A/H3N2 чаще приводит к осложнениям — пневмонии, отиту и осложнениям гонконгского гриппа на сердце (миокардиту). Это касается группы риска: людей с хроническими заболеваниями сердечно-сосудистой системы и лёгких, пожилых, детей, беременных.

В общем, но не в частности: как работает прививка от гонконгского гриппа
Штамм H3N2 (гонконгский грипп) известен почти 60 лет и потому давно включён в состав ежегодных вакцин и вакцинации от гриппа в России. Другое дело, что он чрезвычайно изменчив. Составители вакцин каждый год пытаются угадать направление его развития и использовать наиболее близкий к актуальному вариант.
В этом году в состав вакцин по рекомендации ВОЗ включён штамм, подобный A/Croatia/10136RV/2023 (H3N2). Прививка формирует антигены к H3N2 в общем, то есть не уберегает от заражения на 100%, но снижает риск тяжёлого течения и осложнений гонконгского гриппа.
«Стопроцентно эффективных вмешательств в медицине не бывает, — подчёркивает инфекционист Татьяна Бондаренко. — Цель вакцинации — предотвратить тяжёлое течение заболевания. По моей практике: среди госпитализированных в наш инфекционный стационар привитых нет, потому что они переносят болезнь легко. Госпитализируются с тяжёлыми формами только непривитые пациенты».
В 2025 году в России вакцинировались от гриппа 54% населения. Этого недостаточно для создания коллективного иммунитета и разрыва цепочек заражений, но сами вакцинированные оказались защищены: доля заболевших среди них — 0,004%, то есть четверо из тысячи. В Роспотребнадзоре подчеркнули, что это подтверждает эффективность вакцинации от гриппа A/H3N2.
Оптимальные месяцы для вакцинации — сентябрь и октябрь, однако привиться от гонконгского гриппа в России можно и сейчас, в декабре. Тем более что пик заболеваемости ещё впереди: руководитель Роспотребнадзора Анна Попова (её слова приводят «Известия») и академик РАН Геннадий Онищенко заявили, что наибольшая активность гриппа ожидается к началу новогодних праздников.
Кроме того, без привязки к дате — то есть прямо сейчас — можно с помощью вакцинации защитить себя и от других заболеваний.
«Напоминаю, что национальный календарь прививок для взрослых людей предусматривает вакцинацию от вирусного гепатита B, если вы ранее не были вакцинированы, — говорит Татьяна Бондаренко. — Вводится три дозы с интервалом 0-1-6 месяцев. Кроме того, у нас в регионе сейчас самое время вакцинироваться от клещевого энцефалита. Прививка до последнего времени была доступна в поликлиниках бесплатно по ОМС, и сейчас, когда схлынет грипп, хорошо было бы привиться, подготовиться к следующему сезону. Кроме того, людям пожилого возраста — старше 65 — рекомендуется вакцинация от пневмококковой инфекции. Это важное профилактическое мероприятие, это тоже бесплатно».

Никаких противовирусных: чем лечат гонконгский грипп
Как и всегда при гриппе и ОРВИ, специфическое лечение гонконгского гриппа в России противовирусными препаратами — прерогатива врачей, причём оно эффективно лишь отчасти и подходит далеко не всем. Если оно требуется, в больнице делают тест на определение типа вируса и подбирают препарат, который может подействовать. Самостоятельно подобрать препарат в аптеке невозможно. Ни активно рекламируемые интерфероны, ни популярные иммуномодуляторы не показали ожидаемого эффекта в двойных слепых плацебо-контролируемых исследованиях.
«Точки зрения здесь у разных специалистов из разных стран могут не совпадать, — комментирует Татьяна Бондаренко. — Иммуномодуляторы и интерфероногены используются для лечения в нашей стране, а в других странах к этим препаратам относятся скептически. И важно понимать, о каком именно препарате речь. Есть другие препараты — прямого противовирусного действия, такие как осельтамивир. Он действует непосредственно на сам вирус гриппа и используется в практике как российских, так и зарубежных специалистов. Препарат эффективен, если начать приём как можно раньше от момента появления первых симптомов, но решение об этом должен принимать только врач».
То же касается антибиотиков: они вообще не действуют против вирусов, но должны применяться при вторичной бактериальной инфекции. Решение об этом тоже должен принимать только врач.
«Вирус гриппа может вызвать осложнение — пневмонию, а пневмония может быть разной, — объясняет Татьяна Бондаренко. — Она может быть вирусной, а может быть и бактериальной. Причём для развития бактериальной пневмонии не нужен какой-то посторонний микроорганизм. Собственные микроорганизмы, которые и в норме присутствуют у человека, на фоне гриппа могут вызвать воспалительный процесс в лёгочной ткани. И это уже будет бактериальный процесс, и здесь уже потребуется антибактериальный препарат. А если будет подтверждено, что это вирусная пневмония, то антибиотики не будут эффективны. Поэтому не принимайте их самостоятельно, обязательно обращайтесь за назначением к врачу».
В 99% случаев лечение гонконгского гриппа остаётся симптоматическим. Врач даёт обычные рекомендации, как при любом ОРВИ:
- обеспечить покой и постельный режим;
- пить много тёплой жидкости;
- увлажнить воздух;
- контролировать температуру тела, сбивать только выше 38 °C;
- регулярно проветривать комнату.
Ход лечения должен контролировать врач. При любых необычных симптомах и осложнениях (не сбивается температура, резкие боли в груди, судороги и тому подобное) необходимо снова обратиться к врачу как можно скорее.
Фото: A42.RU